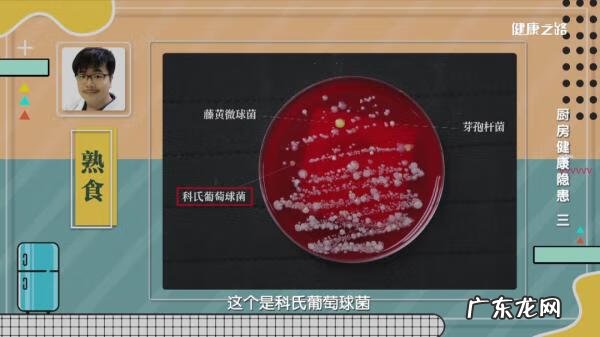
烟曲霉菌是什么东西 烟曲霉菌感染

冰箱不仅是储存食物的好地方,还是滋生细菌的好地方!如何让冰箱摆脱被细菌侵害的烦恼,请听专家这样说~
王晏美 主任医师
中日医院

文章插图
长江日报曾报道过这么一个事件,《头天吃剩下的蛋糕第二天当早餐,节省老太吃完昏迷不醒》,新闻中提到76岁王奶奶因吃了放置在冰箱里隔天的蛋糕发生食物中毒,最终诊断为食用冰箱中过期食物导致的细菌感染 。
冰箱不洁的危害

文章插图
冰箱是狭小密闭的空间,各种食物携带的细菌有可能交叉感染,并且很多嗜冷细菌在3~4℃的环境下,并没有被消灭只是能延缓繁殖 。
放冰箱中的食物可能存在的细菌
鸡蛋:金黄色葡萄球菌

文章插图
金黄色葡萄球菌是葡萄球菌里毒性最强的一类细菌,当金黄色葡萄球菌达到一定量时,会使人出现食物中毒 。
鸡蛋:蜡样芽孢杆菌

文章插图
由蜡样芽孢杆菌引起的食源性疾病被称为“炒饭综合征” ,感染后会造成呕吐、腹泻 。
专家提示:蜡样芽孢杆菌产生的毒素难以被高温杀灭 。
鸡蛋:洋葱伯克霍尔德菌

文章插图
洋葱伯克霍尔德菌来源于洋葱根部,若人体免疫力下降后,接触洋葱伯克霍尔德菌会造成败血症、脑膜炎、腹膜炎 。
专家提醒:冰箱里的鸡蛋架应定期清洗消毒 。
熟食:科氏葡萄球菌、藤黄微球菌、
芽孢杆菌
文章插图
冰箱中的熟食容易携带科氏葡萄球菌、藤黄微球菌、芽孢杆菌,虽对人无明显致病症,但平常也需注意 。
专家提醒:熟食开封后应尽快食用 。
牛奶:链球菌

文章插图
冰箱中的牛奶携带的链球菌毒性强,可引起人体体表、体内的化脓性疾病,例如猩红热、急性上呼吸道感染,甚至还可引起超敏反应性疾病 。
豆腐:酵母菌、荧光假单胞菌、
鲁氏不动杆菌

文章插图
酵母菌、荧光假单胞菌、鲁氏不动杆菌是自然界中常见的细菌,不会导致人患病 。
沙拉酱:烟曲霉菌

文章插图
烟曲霉菌是食品霉变后产生的细菌,若接触可造成眼、鼻、口腔、骨头感染,甚至可引发肺结核 。
腐乳:单增李斯特菌
【烟曲霉菌是什么东西 烟曲霉菌感染】

文章插图
单增李斯特菌是嗜冷菌,是冷藏食品威胁人类健康的主要病原菌之一,它能在冰箱冷藏室内长时间的生长繁殖 。当人体免疫力下降时,遇上单增李斯特菌后,容易造成败血症、脑膜炎、心内膜炎、如果是孕妇感染了单增李斯特菌,会影响胎儿发育 。
蜂蜜、黄豆酱 :葡萄球菌、
蜡样芽孢杆菌

文章插图
蜂蜜无细菌、黄豆酱中存在葡萄球菌、蜡样芽孢杆菌,可造成呕吐、腹泻、化脓性感染 。
专家提醒:蜂蜜常温存放即可、无需冷藏 。
- 入职未满一年的辞退标准是什么
- 男性避孕针百科 男性避孕针剂是什么
- 直通车设置移动折扣是什么意思
- 黑茶的茶叶是什么样子? 黑茶长什么样子
- 黄州快哉亭记中的反是什么意思 黄州快哉亭记
- 奶炖桃胶,有奶块是什么原因 桃胶炖奶是稀还是稠的
- 英菲尼迪q70是什么级别的
- 扇贝是什么季节吃的 扇贝是什么
- 候补车票的意思是什么 可候补车票是什么意思
- 抖音蓝v开通商品橱窗的要求是什么?有哪些规定?
特别声明:本站内容均来自网友提供或互联网,仅供参考,请勿用于商业和其他非法用途。如果侵犯了您的权益请与我们联系,我们将在24小时内删除。
